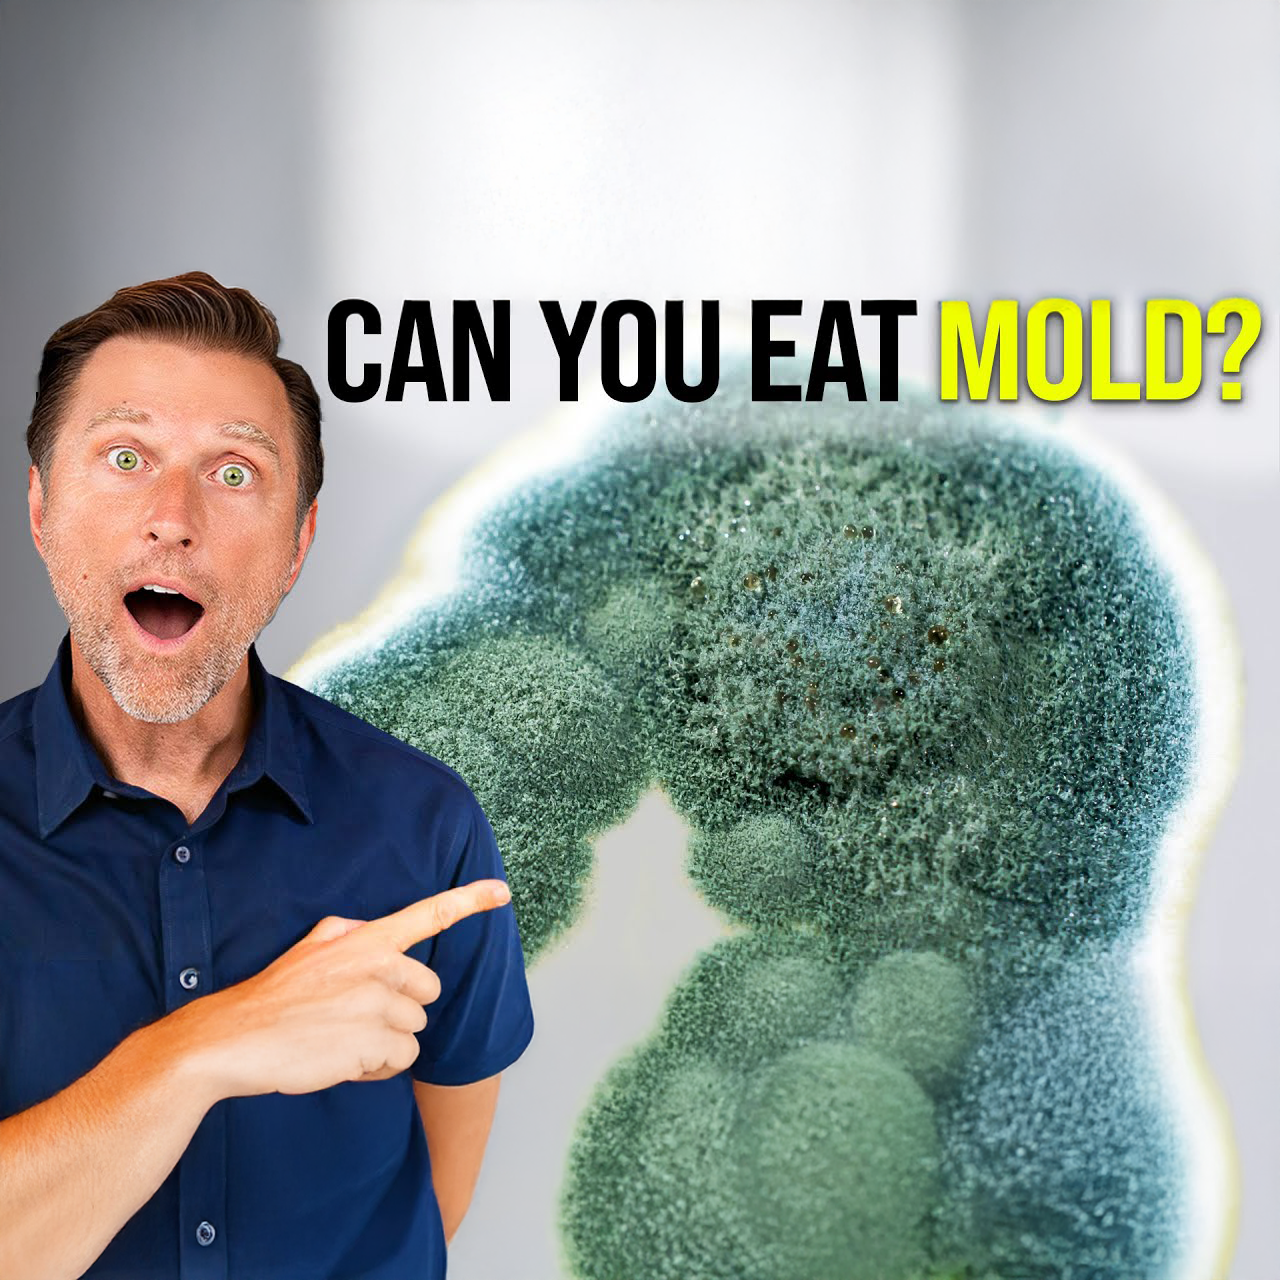

Loading...
About this Episode
Mold toxicity is a common concern, so what about moldy foods like moldy bread or cheese? Can mold make you sick? Is mold dangerous to eat? Find the answers to these questions and more in this quick video!
Watch this episode next: Reset Your Body in 5 Days (With Zero Food)
0:00 Introduction: What happens if you eat mold and fungus?
0:13 Moldy cheese and other moldy food
0:39 Fungus and mold symptoms
1:10 Mold and fungus in the body
3:28 Immune function and mold
4:20 Mold toxicity remedies
Is it safe to eat foods with mold? You probably wouldn’t want to eat moldy bread, but moldy cheese will not negatively affect your health. The mold on cheese does not produce a harmful byproduct like some other molds.
Avoid moldy foods such as peanuts, rice, grains, corn, dried fruit, and coffee. Eating mold on these foods can be harmful to your liver and can even cause cancer.
If you have mold or fungus in or on your body, it’s probably not related to eating mold, but an issue with your microbiome. In a healthy microbiome, you have abundant good bacteria and are typically unaffected by fungus, mold, and yeast.
When your gut bacteria are destroyed, fungus and mold can overgrow. Antibiotics, steroids, high levels of iron, and alcohol are detrimental to your gut microbes. Increased pH in the body can also contribute to the overgrowth of fungi and molds.
Mold and fungus can downgrade your vitamin D receptors. Without sufficient vitamin D, your immune system can not function properly. Increase vitamin D to penetrate this resistance. Whenever you increase your vitamin D intake, you must also increase magnesium, vitamin K2, and zinc.
If you’re deficient in zinc, your thymus will not function properly, inhibiting your immune function. Selenium is also vital to prevent infections.
If you think you may be experiencing fungus or mold toxicity, try the following remedies:
•Activated charcoal
•Bentonite clay
•Chlorophyllin
•Cruciferous vegetables
•NAC
•Propolis
•MCT oil
•Probiotic foods
Dr. Eric Berg DC Bio:
Dr. Berg, age 60, is a chiropractor who specializes in Healthy Ketosis & Intermittent Fasting. He is the author of the best-selling book The Healthy Keto Plan and is the Director of Dr. Berg Nutritionals. He no longer practices, but focuses on health education through social media.
Disclaimer:
Dr. Eric Berg received his Doctor of Chiropractic degree from Palmer College of Chiropractic in 1988. His use of “doctor” or “Dr.” in relation to himself solely refers to that degree. Dr. Berg is a licensed chiropractor in Virginia, California, and Louisiana, but he no longer practices chiropractic in any state and does not see patients, so he can focus on educating people as a full-time activity, yet he maintains an active license. This video is for general informational purposes only. It should not be used to self-diagnose, and it is not a substitute for a medical exam, cure, treatment, diagnosis, prescription, or recommendation. It does not create a doctor-patient relationship between Dr. Berg and you. You should not make any change in your health regimen or diet before first consulting a physician and obtaining a medical exam, diagnosis, and recommendation. Always seek the advice of a physician or other qualified health provider with any questions you may have regarding a medical condition.
#health #keto #ketodiet #weightloss #ketolifestyle #intermittentfasting #lowcarb
Thanks for watching! I hope this increases your awareness about fungus and mold. I’ll see you in the next video.
---
Learn more about your ad choices. Visit megaphone.fm/adchoices
Learn more about your ad choices. Visit megaphone.fm/adchoices
Hosts & Guests
No transcript available for this episode.



